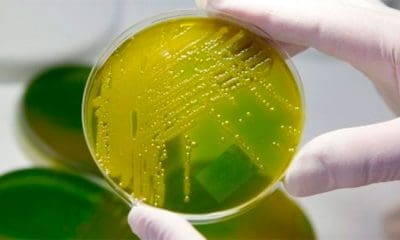
La implementación de este descubrimiento es la primera demostración de una técnica funcional de detección de minas terrestres. | Foto: EFE
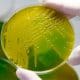
La implementación de este descubrimiento es la primera demostración de una técnica funcional de detección de minas terrestres. | Foto: EFE

Los investigadores lograron frenar la multiplicación del virus y eliminarlo por completo utilizando una avanzada técnica de edición genética.



El experimento podría ser un paso crucial para replicar este tipo de trasplantes en humanos, según el controvertido neurocirujano italiano Sergio Canavero.



Una especie muy avanzada podría haber vivido antiguamente en nuestro planeta y todavía sería posible encontrar rastros de su civilización, asegura un científico estadounidense.



Puebla. Un grupo de investigadores de la Facultad de Ciencias Químicas de la BUAP propone un nanomaterial el cual utiliza baba de caracol, como una alternativa farmacoterapéutica...



A pesar de que las bebidas ‘light’ son promocionadas por las grandes marcas como una alternativa saludable a los refrescos azucarados, estas podrían causar un gran...



Unos científicos estadounidenses comprueban las consecuencias del cambio que ha experimentado el agua del norte del océano Pacífico.



Un video grabado por un dron muestra cómo el mamífero marino elige cuidadosamente qué bancos de krill atacar en función de su tamaño. ¿A qué se...



Los científicos han utilizado una técnica de electroencefalografía de alta densidad que registra la actividad eléctrica para investigar el vínculo entre la actividad cerebral y los...



Se argumenta que el consumo de té es beneficioso para la salud por contener antioxidantes, catequinos, polifenoles, etc.

Un equipo de científicos de la Universidad Hebrea de Jerusalén modificó moléculas en bacterias vivas para que estas emitan una señal fluorescente cuando estén en contacto...